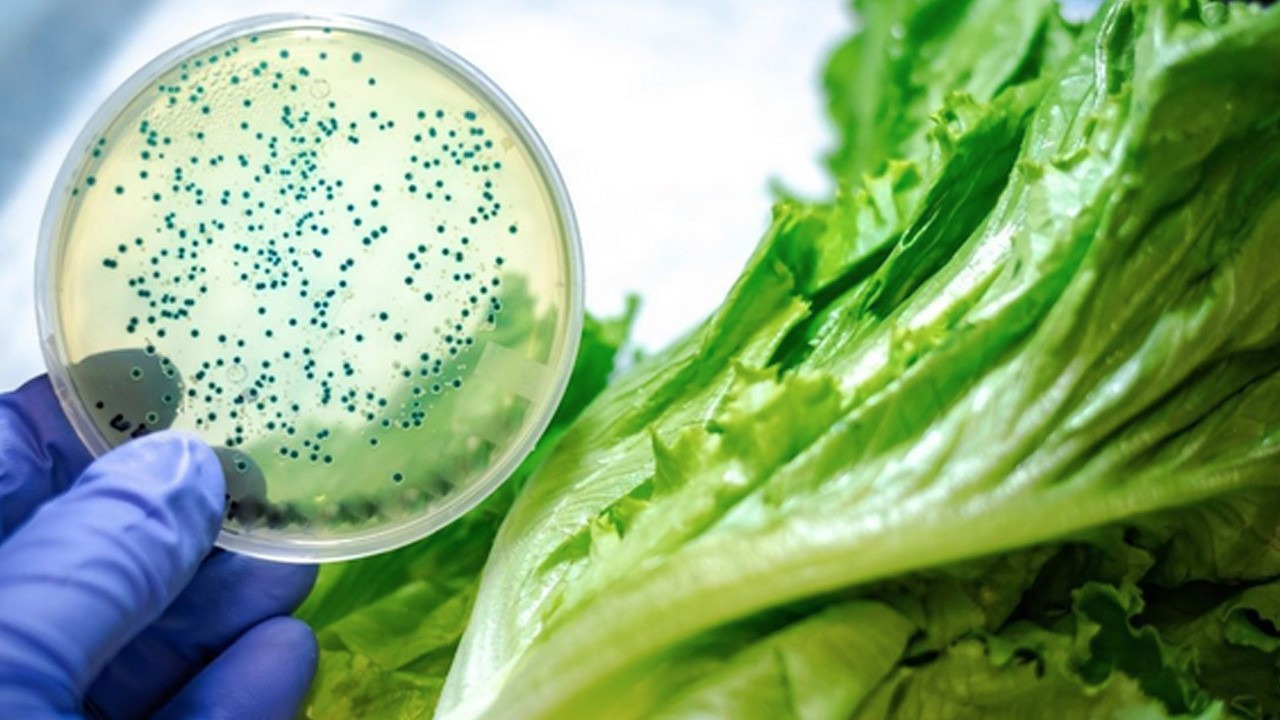
Mutfağınızdaki tehlike! Çapraz bulaşma sağlığınızı ciddi tehdit ediyor

Unutulan fay hattı orada uyandı: Deprem 23 milyon etkilenecek! Geleceği yutan felaket
Milli İradenin Sesi Yeni Akit
Türkiye ve dünyadaki gelişmeleri yakından takip etmek için Google listenize Yeni Akit'i ekleyin.

Bu hafta ABD Güney Kaliforniya'da meydana gelen deprem, "Büyük Deprem"in yaklaştığına dair korkuları alevlendirirken, geleceği yutan felaket olarak bahsedilen deprem hakkında uzmanlar depremin beklenmedik bir kaynaktan gelebileceği konusunda uyardı. Elsinore fayıyla ilgili endişeleri yeniden gündeme getirdi.
Bu hafta ABD Güney Kaliforniya'da meydana gelen deprem, "Büyük Deprem"in yaklaştığına dair korkuları alevlendirirken, Deprem 100-200 yıldır orada duruyor, uzmanlar depremin beklenmedik bir kaynaktan gelebileceği konusunda uyardı.
ABD'nin Güney Kaliforniya’da bu hafta meydana gelen 5.2 büyüklüğündeki deprem, uzun süredir sessizliğini koruyan Elsinore fayıyla ilgili endişeleri yeniden alevlendirdi.
Tüm dikkat San Andreas fayına yönelse de uzmanlar, "Büyük Deprem"in beklenmedik bir kaynaktan, Elsinore fayından gelebileceği konusunda uyardı.
Elsinore fayı, ABD-Meksika sınırından başlayarak San Diego ve Riverside ilçeleri üzerinden Los Angeles’a kadar yaklaşık 160 kilometreye uzanıyor. Kaliforniya Teknoloji Enstitüsü’ne göre bu fay hattı, bölgedeki en büyük risklerden birini oluşturuyor.
Sismolog Dr. Lucy Jones, Elsinore’un 7.8 büyüklüğünde bir deprem üretme potansiyeline sahip olduğunu belirtiyor. 1910’dan bu yana 6.0’ın üzerinde bir deprem üretmemiş olan bu fay, her 100-200 yılda bir büyük sarsıntı yaşatma eğiliminde.
Elsinore fayında meydana gelebilecek büyük bir deprem, San Diego’dan Los Angeles’a ve hatta Las Vegas’a kadar etkili olabilir. 2017 yılında ABD Jeoloji Araştırmaları Kurumu (USGS), Elsinore’dan başlayarak Whittier fayına kadar uzanan 7.8 büyüklüğünde bir depremin simülasyonunu gerçekleştirdi. Bu senaryo, Los Angeles genelinde yapısal hasar, can kaybı ve ekonomik yıkım gibi ciddi sonuçlara yol açabileceğini gösterdi.
"BÖLGEDE SİSMİK AKTİVİTE ARTIYOR"
Dr. Jones’a göre, son yıllarda bölgede 1980’lerdeki gibi artan bir sismik hareketlilik dikkat çekiyor. 1990’larda meydana gelen Landers (1992) ve Northridge (1994) depremleri bölgedeki tektonik stresi azaltmış, bu da uzun bir sessizlik dönemine neden olmuştu. Ancak artık bu sessizliğin sona erdiği düşünülüyor.
San Andreas fayı üzerindeki olası bir 8.0 büyüklüğündeki depremin Kaliforniya genelinde bin 800 kişinin ölümüne, 50 bin kişinin ise yaralanmasına neden olabileceği tahmin ediliyor. Ancak uzmanlar, aynı ölçekte bir depremin Elsinore fayında da meydana gelebileceğine dikkat çekiyor.